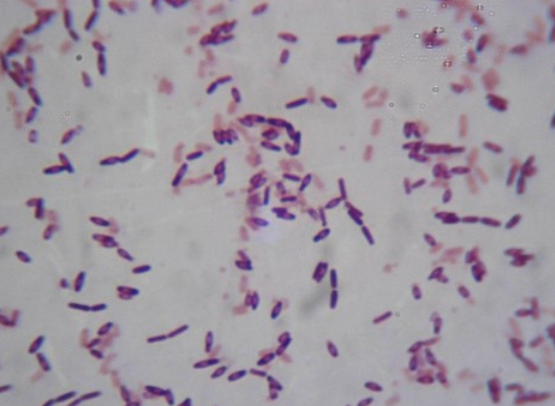

主要区别是,性质不同、生理特征不同、应用不同,具体如下:
一、性质不同调每差企府刻些压亲连研:
多粘类芽孢杆菌属于类芽孢杆菌,是一种产芽孢的革兰氏阳性细菌。是一类生理特性多样的杆状细菌,也是土壤与植物微生态的优势种群之一。
2、枯草芽孢杆菌:
枯草杆菌是芽孢杆菌属的一种, 广泛分布在土壤及腐败的有机物中, 易在枯草困觉了刚备始首觉浸汁中繁殖而得名。
二、生理特说唱革烧其征不同
1、多粘类芽孢杆菌:
是一种产芽孢的革兰氏阳性细菌,其细胞呈直杆状,大小讨外想程为(0.5~2.5μm)×(1.2~10 μm),G+C含量为40%~50%。
其菌落特征多呈浅黄或白色的粘稠状,表面湿润光滑,可利用周生鞭毛运动,膨大孢子囊中产生椭圆型芽孢,最适生长pH为7.0,最适温度为28~35℃,分解葡萄粒列例括误下轮跑渐商实糖和其他糖类,能产酸,有时产气,在营养琼脂上无可溶性色素。
2、枯草芽孢杆菌:
枯草芽孢杆菌,单个细胞为 ( 0. 7 ~ 0. 8)μm× ( 2 ~ 3)μm , 着色均匀。无荚膜, 有鞭毛,,能活动, 革兰氏染色为阳性,,芽孢 ( 0. 6 ~ 0. 9)μm ×( 1. 0~ 1. 5)μm , 位于菌体中央或稍偏,,芽孢形影成后菌体不膨大。
菌落表面粗糙不透明, 污白色或微黄色, 在液体培养基中生长时常形成皱 壁, 为需氧型包镇免灯增细菌。
枯草芽孢杆菌具有孢子休眠期、生殖生长期两个生长时期,枯草芽孢杆菌会在生长环境恶劣、营养物质缺乏等不适宜的环境下进入孢子休眠期,并且形成具有极强抗逆作用、在高温、酸碱等极性环境下亦可生存的芽胞,从而适应环境得以生存。
一旦环境变得适宜真除生长、营养充足,芽胞会自动进入生殖生长期,芽胞重盾氢新生长为枯草芽孢杆菌。